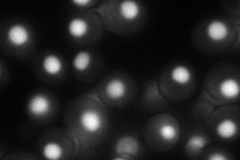
YNL133C
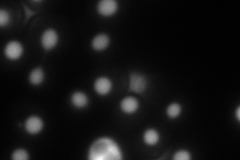
YNL133C
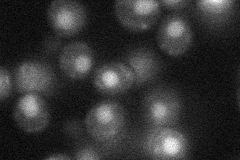
YNL133C
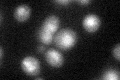
YNL133C

View description
Protein of unknown function, required for survival upon exposure to K1 killer toxin; proposed to regulate double-strand break repair via non-homologous end-joining
Localization:
Intensity:
Fold change:
Significance:
-
C’ GFP library in SD

nucleus23.95 -
N' NOP1pr-GFP in SD
nucleus93.5397 -
N' TEF2pr-mCherry in SD
nucleus103.223 -
N' NATIVEpr-GFP in SD
nucleus29.9076 -
N' TEF2pr-VC and Cyto-VN in SD

#N/A0 -
C’ GFP library in SD+DTT
nucleusN/AN/ANo -
C’ GFP library in SD+H2O2

nucleusN/AN/ANo -
C’ GFP library in Starvation Media

nucleusN/AN/AYes -
C’ GFP library on the background of Pup2-DaMP

nucleus -
C’ GFP library on the background of CCT mutant

nucleusN/AN/ANo
